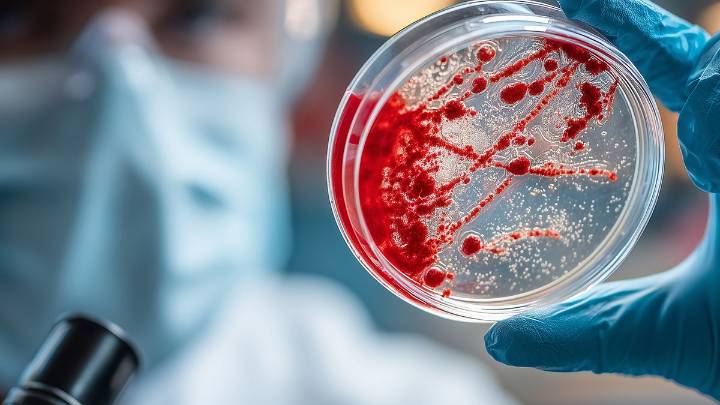
Cómo frenar el avance de las superbacterias en Rosario

Las superbacterias avanzan en todo el mundo, y Rosario no queda al margen de esta catástrofe. Son microorganismos que lograron hacerse resistentes a los antibióticos disponibles y producen infecciones que no se pueden controlar, provocando secuelas graves o la muerte de las personas. ¿Cuál es el panorama en la ciudad en relación a la resistencia bacteriana? Este problema que las organizaciones de salud más importantes han catalogado como una gran amenaza mundial, es encarado en la ciudad de distintas maneras: investigación, prevención, detección temprana y la búsqueda de tratamientos eficaces.
Por distintas causas, una de cada seis infecciones bacterianas ya no responde a las drogas habituales. Una de las razones ha sido el abuso que se hizo durante años y años al tomar antibiót

 La Capital
La Capital
La Nación
La Nación Diario La Prensa
Diario La Prensa People Top Story
People Top Story OK Magazine
OK Magazine CBS News
CBS News ABC30 Fresno Sports
ABC30 Fresno Sports Truthout
Truthout AlterNet
AlterNet